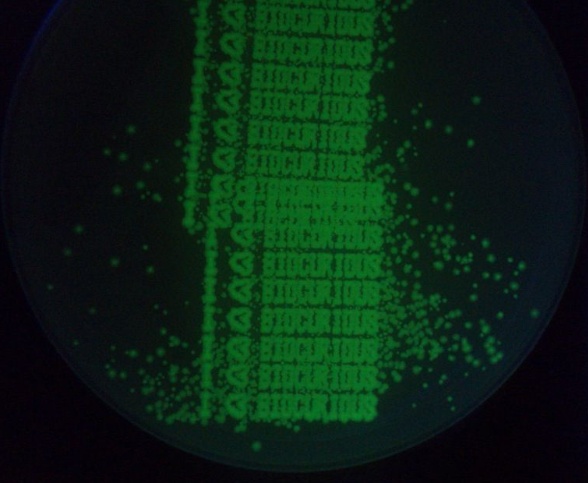
image

Протезы для людей и животных, 3д печать космических конструкций, еды и ботинок, повышение точности печати, новые материалы, новый софт.
Куча проектов на краудфандинговых платформах.
Ну и пистолеты, куда ж без них.

Китай, Япония, Австралия, США, Нидерланды, Африка и Гаити, похоже что 3д печать есть во всех уголках мира.
В 2014 году 3д печать отправится в космос.
(Обзор достижений 3д печати 2012 года здесь )
Читаем чего достигли за 2013 год под катом (54 фото)
Январь
Китайцы напечатали 5 метровую цельную запчасть для самолета из титана
Технология селективного лазерного спекания в действии

Детальки поменьше


Вот самолет, в котором используют детали напечатанные на 3д принтере

Хакерспейс BioCurious предлагает всем биопринтер для самостоятельной сборки на основе HP 5150 inkje
(первая надпись где вместо чернил — "кишечная палочка")
Европейское космическое агенство проводит эксперименты по постройке убежища на Луне при помощи 3д принтера


полуторатонный строительный блок
Февраль
Команда ученых из Шотландии, впервые, используя 3д принтер, печатают трехмерные ткани из стволовых клеток

Статья PDF
Машина Urbee 2, напечатанная на 3д принтере, готова к производству
habr.habrastorage.org/post_images/ebe/c36/076/ebec36076cc50e8348a91a8c22fda86e.jpg
Президент Обама сказал, что технология 3д печати «имеет потенциал коренным образом изменить способ, которым мы производим большинство вещей»

В феврале началась шумиха с 3doodler — 3д карандашом, который может «рисовать в воздухе».
За несколько часов они собрали более миллиона долларов на кикстартере.

Статьи на хабре по этому поводу:
Ручкой 3Doodler можно рисовать трёхмерные объекты прямо в воздухе
Наш ответ 3doodler`у. Собран за 20 минут
3Doodler спешит к вам! (Бонус: обзор клонов)
В ноябре «карандаш» доставили в Россию — первый(и последний) обзор
Ученые напечатали искусственное ухо

оригинал статьи
Nike представили первые в мире бутсы, напечатанные на 3д принтере

4д печать. Самотрансформиющиеся объекты

Видео о 4д печати на TED
Март
Правительство Сингапура намерено инвестировать 500 млн $ в развитие отрасли 3д печати.

3д печать позволяет создавать лоу-кост импланты с учетом анатомических особенностей пациентов

83-х летний изобретатель выиграл 40.000 $ в конкурсе за свой «сделай-сам» экструдер

Апрель
Ученые из оксфордского университета заявили, что их 3д принтер способен создавать материалы с некоторыми свойствами живой ткани

Создан 3д сканнер, способный получать изображения с расстояния 1 км

Китайское правительство намерено вложить $6.5M в развитие технологий 3д печати

GE печатает топливные форсунки для авиадвигателей

Май
Пистолет «Освободитель»: 100 тысяч скачиваний за двое суток

Напечатанное ухо способно улавливать радиочастоты

NASA выделило грант в размере $125K на разработку пищевого 3д принтера для астронавтов, которые полетят в дальний космос

Спасли жизнь ребенку, напечатав трахею

NASA планирует отправить 3д принтер на МКС в августе 2014

Японцы напечатали углеродного зайчика размером с бактерию

Китайцы показали самую большую деталь для боевого самолета, напечатанную на 3д принтере

Июнь
Британское правительство инвестирует £14.7m в проекты, связанные с 3д печатью
Из полимеров создана «искусственная кость» прочность которой в 22 раза выше чем прочность составного компонента

Microsoft встроил поддержку 3д принтеров в Windows 8.1
Для раненой утки напечатали лапку

Июль
MIT разрабатывает софт, упрощающий работу с составными материалами

Британские дети будут изучать робототехнику и 3д печать с 5 лет
Статья в Telegraph
Август
Двигатель для ракет, напечатанный на 3д принтере прошел тест NASA, что явилось точкой отсчета для многих нововведений по уменьшению затрат на производство запчастей

Ученые из Мельбурна предложили технологию, позволяющую вырастить «собственный хрящ» для коленного сустава из стволовых клеток используя 3д принтер

Ученые из MIT разработали легковесную структуру, мельчайшие детали которой могут быть напечатаны на 3д принтере и собраны подобно конструктору ЛЕГО. Планируемое использование — в конструкции самолетов, космических кораблей, дамб и мостов.

Первая в мире полномасштабная архитектурная инсталляция Echoviren

Сентябрь
Прорывная технология — печать разнородными материалами, как органическими, так и неорганическими материалами: керамикой, металлом, пластиком и даже биологическими клетками

Разработчики из Disney представили софт, который позволит вам создавать и распечатывать на 3д принтере механические игрушки

3д принтер за 100$ — The Peachy Printer

Ученые из Австралии при помощи ручного 3д сканера создали модель Пизанской башни

Ученые из Нидерландов при помощи 3д сканера и 3д принтера создали репродукции картин Рембрандта и Ван Гога

Октябрь
Британия выделила грант на £500K для оснащения 60 школ 3д принтерами

HP планирует в середине 2014 года выйти на рынок 3д печати

Ученые открыли, что в процессе 3д печати можно использовать природные компоненты (витамин B2) для создания имплантов

На Гаити появился 3д принтер

Microsoft предложили технологию, которая может превратить любой смартфон в 3д сканер

Ноябрь
Вышла программа для шифрования 3D-моделей

Желатиновые биочернила для печати органов

Первый в мире полностью металлический пистолет напечатанный на 3д принтере

Ученые напечатали 20 слоев ткани печени, которая прожила 40 дней

статья на хабре
Революция в текстильной промышленности

Настольный 3д принтер печатающий металлом


Прогресс в изготовлении литий-ионных аккумуляторов при помощи 3д принтеров.


Теперь аккумуляторы могут быть меньше песчинки и тоньше человеческого волоса. Их можно использовать в имплантах и в роботах-насекомых.


Ошеломляюще, парадоксально! Не верю своим глазам!